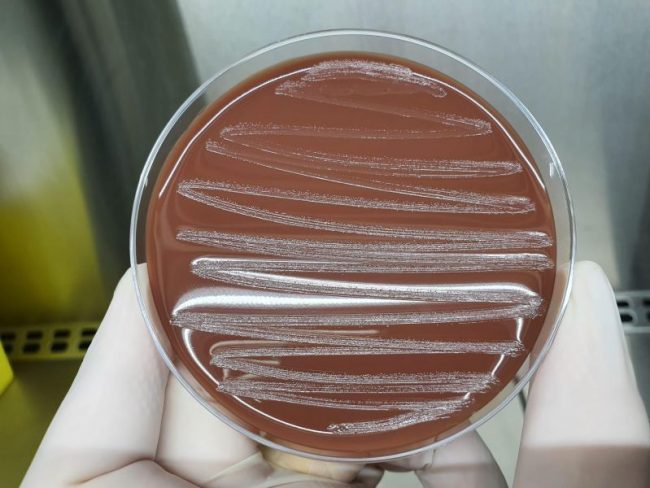

Glaesserella parasuis
La Glaesserella parasuis, anteriormente conocida como Haemophilus parasuis, es una bacteria comensal habitual de las vías respiratorias de los cerdos. En las condiciones adecuadas, ocasiona brotes agudos de enfermedad, ataca las superficies serosas que recubren las articulaciones, intestino, pulmones, corazón y cerebro, causando neumonía, infección del pericardio, peritonitis y pleuritis. Se puede observar en granjas…